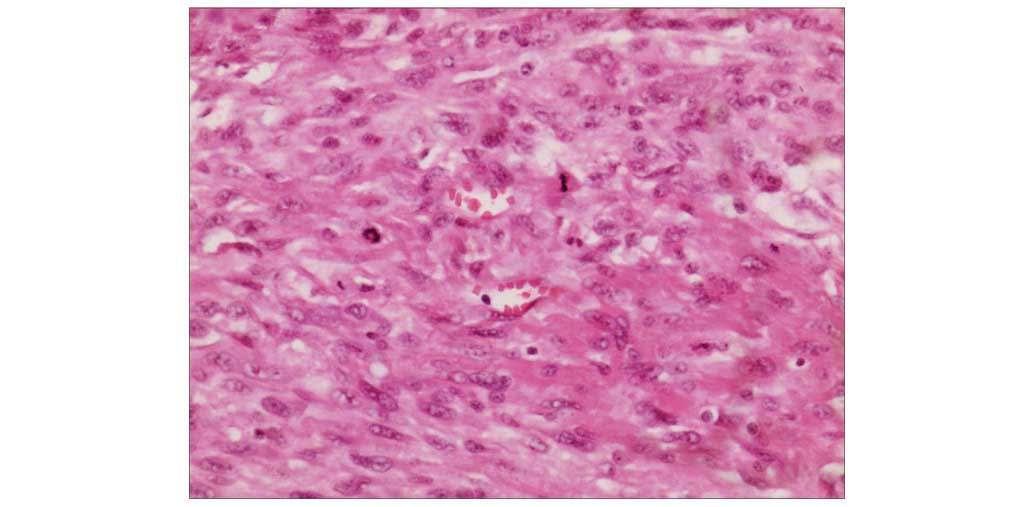

Introduction
Primary thyroid leiomyosarcoma (LMS) is an extremely
rare soft tissue cancer, with only 22 reported cases to date
(1–19). LMS is commonly observed in the
gastrointestinal tract, retroperitoneum and pelvis (10,16);
however, only 0.014% of LMS cases develop in the thyroid gland
(6,10,11,13,18,19),
with an estimated 1-year survival rate of 5–10% (13,17).
Primary thyroid LMS most commonly occurs in the elderly with a
predilection for female patients, and typically presents as a
painless, rapidly growing neck mass. Ultrasound, computed
tomography (CT) and magnetic resonance imaging (MRI) may be used to
diagnose thyroid tumors. A diagnosis of LMS is dependent on the
presence of smooth muscle-actin (SMA), which may be identified by
immunohistochemical staining. The standard primary treatment for
primary thyroid LMS is radical surgery. The long-term prognosis is
poor and ~50% of patients succumb to the disease within a short
period of time after diagnosis (10,14). The
present study reports the case of an 83-year-old male patient
diagnosed with primary thyroid LMS and the relevant literature is
comprehensively reviewed.
Case report
In December 2013, 83-year-old male patient presented
to the Chinese People's Liberation Army General Hospital (Beijing,
China) with a neck mass that had grown rapidly in the 3 months
prior to admission, as well as hoarseness and bucking, which had
been apparent for 1 month. No evidence of dyspnea or dysphagia were
identified. The patient's past medical history included a diagnosis
of thyroid carcinosarcoma with a right thyroid lobectomy performed
in June 2013 (6 months previously), as well as a diagnosis of
prostate cancer, which was treated with prostatectomy and
orchiectomy in May 2010 (3 years previously), and diabetes treated
with insulin from August 2010 (2 years prior to admission). The
patient reported no radiation exposure or any family history of
cancer.
Palpation revealed a large, irregular, firm, tender
and immovable tumor mass in the right anterior neck. The trachea
was displaced to the left. The results of a serum thyroid function
test were as follows: Free triiodothyronine, 5.39 pmol/l (normal
range, 2.76–6.3 pmol/l); free thyroxine, 26.79 pmol/l (normal
range, 10.42–24.32 pmol/l); and thyroid stimulating hormone, 0.084
mU/l (normal range, 0.35–5.5 mU/l). Laryngoscopy (ENF-V2; Olympus
Corporation, Tokyo, Japan) revealed right vocal cord paralysis.
Ultrasonography (iU22; Philips, Amsterdam, Holland) of the thyroid
identified a 12.2×10.1-cm, ill-defined hypoechoic mass arising from
the right thyroid lobe. CT (uCT S-160; United Imaging, Shanghai,
China) revealed an ill-defined, low-density mass replacing the
right thyroid lobe that extended to the substernal area and
compressed the esophagus. The trachea was widely displaced to the
left lateral neck. Contrast-enhanced CT (Brilliance iCT 728306;
Philips Medical Systems, Cleveland, OH, USA) showed inhomogeneous
enhancement, necrosis and cystic degeneration within the tumor
(Fig. 1). No evidence of distant
metastases was identified.
Surgical exploration revealed a firm, irregular,
encapsulated tumor measuring 13.5×10×5 cm in size that occupied the
entire right thyroid lobe. Subsequently, a right thyroid lobectomy
was performed. The tumor was dissected at the lower edge of the
submaxillary gland and parotid gland on the surface of the trachea
and thyroid cartilage. No lymph node metastasis was identified.
The resected specimen (4-µm) was fixed in 10%
buffered formalin (Sigma-Aldrich, St. Louis, MO, USA), processed
and embedded in paraffin (Leica, Mannheim, Germany) using standard
histological methods (19). Staining
was visualized using an inverted microscope (TE2000-U; Nikon
Corporation, Tokyo, Japan). Hematoxylin and eosin (Sigma-Aldrich)
staining revealed interlacing fascicles of spindle tumor cells in
the tumor (Fig. 2).
Immunohistochemistry was performed using a standard avidin-biotin
immunoperoxidase technique (19). The
monoclonal mouse anti-human actin (clone, 1A4; cat. no. IR611;
dilution, 1:100; Dako, Glostrup, Denmark) was used for SMA staining
(Fig. 3). The monoclonal mouse
anti-human vimentin (clone, V9; cat. no. AX074-YCD; dilution,
1:200; BioGenex, USA) was used for vimentin staining. The
monoclonal mouse anti-human Ki-67 antigen (clone, MIB-1; cat. no.
IR626; dilution, 1:200; Dako) was used for Ki-67 staining. The
monoclonal mouse anti-human cytokeratin (clone, AE1/AE3; cat. no.
IR620; dilution, 1:100; Dako) was used for cytokeratin staining
(Fig. 4). Immunohistochemical
staining was positive for SMA (Fig.
3), vimentin and Ki-67 (50–75%), and negative for cytokeratin
(Fig. 4). No epithelial
differentiation was identified. The final diagnosis was primary
thyroid LMS, and was determined according to the following
guidelines: i) Morphologically similar to LMS, with the tissue
comprised of spindle cells arranged in fascicles with elongated and
centrally located cell nuclei; ii) the assessment of cellular
atypia, necrosis and mitotic activity per high-powered field, which
can differentiate LMS from benign tumors; and iii) the presence of
muscle specific markers, including SMA positivity (20).
The patient received 2 cycles of adoptive transfer
of immune cell therapy on January 2014 and February 2014.
Peripheral blood mononuclear cells (PBMC) were isolated from the
patient on the day prior to operation allowing time to prepare the
immune cells. The patient was sequentially injected intradermally
with autologous tumor lysate-loaded dendritic cells (DCs)
(>1×108) at multiple areas in the clavicular region
on day 13 post-PBMC collection, and infused intravenously with
DC-activated T lymphocyte cells (>1×1010) on day 14
post-PBMC collection. However, 2 months after the completion of
immunotherapy, tumor recurrence without multiple metastases was
identified in the right neck. The patient's general condition
deteriorated gradually and he succumbed to the disease 5 months
after the second surgery.
Discussion
The first case of LMS of the thyroid gland was
reported in 1969; in this case, the tumor metastasized to the heart
and brain (1). To date, only 22 cases
of primary thyroid LMS have been reported in the literature
(Table I) (1–19).
However, the number of reported cases is increasing due to the
utilization of immunohistochemical methods to identify SMA
positivity for diagnosis (6).
 | Table I.Summary of the 22 cases of primary
leiomyosarcoma of the thyroid gland previously reported in the
literature. |
Table I.
Summary of the 22 cases of primary
leiomyosarcoma of the thyroid gland previously reported in the
literature.
| Case no. | Gender | Age (years) | Chief complaint | Location | Diameter (cm) | TFT | Treatment | Follow-up
(months) | Recurrence | Metastasis | Outcome | Ref. |
|---|
| 1 | F | 74 | Rapidly growing neck
mass, dysphagia, pain, anorexia, weight loss | Both lobes,
isthmus | 12.0 | NA | Biopsy,
chemotherapy | 1 | NA | Cervical, axillary,
and mediastinal LN, lung, heart, liver, kidneys pancreas, small and
large intestines, brain | DOD | (1) |
| 2 | M | 82 | Rapidly growing neck
mass, hoarseness | Right lobe,
isthmus | 5.5 | Normal | Lobectomy, LN
dissection, partial tracheal resection | 4 | Y | Regional LN | DOD | (2) |
| 3 | NA | NA | NA | NA | NA | NA | NA | 12 | NA | Cervical LN | AWD | (3) |
| 4 | F | 54 | Mass noted at routine
examination | Left lobe | 3.5 | Normal | Lobectomy | 15 | N | None | NED | (4) |
| 5 | F | 72 | Growing neck
mass | Right lobe | 3.0 | Normal | Lobectomy, LN
dissection | 51 | N | Bone | DOD | (5) |
| 6 | F | 58 | Growing neck
mass | Left lobe | 5.0 | Normal | Total
thyroidectomy, LN dissection | 25 | N | None | NED | (6) |
| 7 | F | 64 | Growing neck
mass | Right lobe | 7.5 | NA | Subtotal tumor
resection | 5 | NA | Lung, liver,
peritoneum, pleura | DOD | (7) |
| 8 | M | 45 | Rapidly growing
neck mass, weight loss | Left lobe | 9.0 | NA | Hemithyroidectomy,
chemotherapy | 11 | N | Lung | AWD | (7) |
| 9 | M | 68 | Rapidly growing
neck mass, hoarseness | Left lobe | 1.9 | NA | Subtotal tumor
resection | 18 | NA | Lung | DOD | (7) |
| 10 | M | 83 | Growing neck mass,
dysphagia | NA | 5.5 | NA | Excision | 3 | N | Lung | DOD | (7) |
| 11 | F | 90 | Rapidly growing
neck mass, dyspnea | NA | 8.0 | NA | Subtotal tumor
resection, tracheostomy | 2 | NA | NA | DOD | (8) |
| 12 | M | 6 | Neck mass | Left lobe | 5.0 | Normal | Gross tumor
resection | 4 | N | Lung, liver | AWD | (9) |
| 13 | F | 66 | Rapidly growing
neck mass | Left lobe | 8.5 | TSH↑ | Subtotal
thyroidectomy, total laryngectomy | 3 | Y | Lung | DOD | (10) |
| 14 | M | 43 | Rapidly growing
neck mass | Left lobe | 6.0 | Normal | Wide excision, LN
dissection, chemotherapy | 6 | Y | Lung | DOD | (11) |
| 15 | F | 83 | Left arm pain | Right lobe | 9.0 | Normal | Palliative
treatment | 2 | NA | NA | DOD | (12) |
| 16 | F | 63 | Rapid growing neck
mass, pain during swallowing, weight loss | Left lobe | 7.0 | Normal | Total
thyroidectomy | 5 | N | Lung, liver, bone,
peritoneum | DOD | (13) |
| 17 | F | 65 | Rapidly growing
neck mass, weight loss, onset of cough | Right lobe | 7.5 | Normal | Total
thyroidectomy, bilateral central neck dissection, cervical
thymectomy, chemotherapy | 4 | N | None | NED | (14) |
| 18 | M | 39 | Rapidly growing
neck mass, hoarseness | Right lobe | 3.5 | Normal | Total
thyroidectomy, LN dissection, radiotherapy | 48 | N | None | NED | (15) |
| 19 | F | 72 | Rapidly growing
neck mass | Left lobe | 5.0 | Normal | Lobectomy | 2 | NA | NA | DOD | (16) |
| 20 | M | 56 | Rapidly growing
neck mass, hoarseness, dysphagia | Left lobe | 3.0 | Normal | Total
thyroidectomy, central neck dissection | 8 | N | None | NA | (17) |
| 21 | M | 65 | Left arm pain | Left lobe,
isthmus | 16.0 | Normal | Total
thyroidectomy, partial esophagectomy | 60 | N | None | NED | (18) |
| 22 | F | 64 | Rapidly growing
neck mass | Left lobe | 7.0 | Normal | Total
thyroidectomy | 3 | N | Lung, liver | DOD | (19) |
| 23 | M | 83 | Rapidly growing
neck mass, hoarseness, bucking | Right lobe | 13.5 | FT4↑, TSH↓ | Lobectomy,
immunotherapy | 5 | Y | None | DOD | Current case |
Primary thyroid LMS most commonly occurs in elderly
patients, with an average age of 65.3 years (range, 39–90 years).
However, a case of Epstein-Barr virus-associated thyroid LMS was
reported in a 6-year-old male patient with congenital
immunodeficiency (9). Primary thyroid
LMS exhibits a slight predilection for female patients (female:male
ratio, 1.3:1). Primary thyroid LMS most commonly presents as a
painless, rapidly growing neck mass. Additional symptoms include
hoarseness, dysphagia, dyspnea and weight loss, and arm pain is
occasionally reported (1,2,5–8,10,13–19).
According to the literature, the majority of patients with LMS are
euthyroid (2,4–6,11–14,15–19).
Notably, none of the previous cases reported a history of radiation
exposure. Tumor diameter varies between 1.9 and 16 cm (mean
diameter, 6.6 cm), and tumors are solitary, with the majority
confined to a single lobe (4–7,9–19).
Imaging results may reveal a variety of
characteristics regarding primary thyroid LMS. For example, thyroid
scans may identify a cold nodule, or an enlarged gland with areas
of increased or decreased uptake of radioactive iodine (1,4,7); ultrasound may reveal an ill- or
well-defined hypoechoic mass, a solid or partially cystic nodule,
or a calcified nodule (2,4–6,10); CT may show a low-density mass with
dense calcification and necrosis, a well-demarcated mass, a soft
tissue mass with calcification or, in certain cases, direct
tumorous invasion of the adjacent structures (5,6,10); and MRI may reveal a mass of
intermediate signal on T2-weighted images and an isointense mass on
T1-weighted images with a fair gadolinium enhancement (10).
Fine needle aspiration cytology is also used for the
preoperative diagnosis of thyroid LMS (18). Histologically, the presence of
interlacing fascicles or bundles of eosinophilic spindle cells and
positivity for SMA on immunohistochemical examination may diagnose
thyroid LMS (10,16). LMS tumor cells in the thyroid and
other organs typically stain positively for SMA, vimentin and
desmin (19), and negatively for
cytokeratin, thyroglobulin, calcitonin, S100 and chromogranin
(16). Notably, negative staining for
cytokeratin, a protein composed of keratin-containing intermediate
filaments found in the intracytoplasmic cytoskeleton of epithelial
tissue, indicates a non-epithelial tumor. Furthermore, c-kit is
rarely expressed in LMS, although a case of c-kit overexpression in
primary thyroid LMS has been previously reported (11).
In the present case, the clinical manifestation (a
rapidly growing neck mass confined to a single lobe) and
pathological features (SMA+, vimentin+,
Ki-67+ and cytokeratin−) were similar to
those reported in the literature. However, the current patient was
older than previous cases and had an abnormal thyroid function. The
patient was initially misdiagnosed with thyroid carcinosarcoma
prior to the first thyroidectomy as cytokeratin staining, which
serves an important role in distinguishing epithelioma and
non-epithelial tumors, was not taken into account.
The major histopathological differential diagnoses
of primary thyroid LMS include anaplastic carcinoma of the thyroid,
spindle cell variant of medullary thyroid carcinoma, spindle cell
tumor with thymus-like differentiation, and uncommon primary and
metastatic tumors of the thyroid with predominant spindle cells
(19). The World Health Organization
categorizes carcinosarcoma as a variant of anaplastic carcinoma.
However, Agrawal et al (21)
proposed that ‘thyroid carcinosarcoma’ should be considered a
distinct entity. Unlike anaplastic carcinoma originating from
epithelial cells, carcinosarcoma is hypothesized to originate from
malignant epithelial (carcinomatous) and mesenchymal cells
(21). Positive immunohistochemical
staining for thyroglobulin (in carcinomatous cells), and vimentin
and S100 (in mesenchymal cells) confirms a diagnosis of
carcinosarcoma (22). Thus,
particular care is required when diagnosing primary thyroid LMS due
to variant differential diagnoses.
The etiology of primary thyroid LMS remains unclear,
however, certain authors have postulated that it may originate from
the smooth muscle in the vascular walls (6,10,14,16–18). In
addition, LMS appears to invade adjacent tissue rather than
metastasizing to regional lymph nodes (6,11), thus,
radical surgery is essential (6,10,11,16,17,19).
The complexity of the procedure depends on tumor size and adjacent
tissue/organ involvement. Previous studies have shown that, in
patients with a large or locally aggressive tumor, the more
aggressive the procedure, the more beneficial it is (18,19).
However, aggressive surgical resection with adjuvant chemotherapy
and radiation therapy have not been shown to affect recurrence
rates or long-term survival of patients with primary thyroid LMS
(14,15). Of all previously published cases
(1–19)
and the present case, only the patient in the current study
received immunotherapy. Certain studies suggested that
immunotherapy has an effect on leimyosarcomas, however, the present
case indicates that immunotherapy does not affect the outcome of
primary thyroid LMS (23).
In conclusion, the present study reported a rare
case of primary thyroid LMS in an 83-year-old male patient who
underwent thyroid lobectomy and immunotherapy, but ultimately
succumbed to the disease 5 months after undergoing a second
surgery. Primary thyroid LMS is extremely rare and difficult to
diagnose. Immunohistochemical staining is important for
establishing a diagnosis of primary thyroid LMS and distinguishing
the disease from anaplastic carcinoma. The standard primary therapy
is radical surgery, as, to date, adjuvant chemotherapy, radiation
therapy and immunotherapy have not proven beneficial. The long-term
prognosis of primary thyroid LMS is poor. Therefore, careful
evaluation of a patient's condition and comprehensive individual
treatment are essential.
References
|
1
|
Adachi M, Wellmann KF and Garcia R:
Metastatic leiomyosarcoma in brain and heart. J Pathol. 98:294–296.
1969. View Article : Google Scholar : PubMed/NCBI
|
|
2
|
Kawahara E, Nakanishi I, Terahata S and
Ikegaki S: Leiomyosarcoma of the thyroid gland. A case report with
a comparative study of five cases of anaplastic carcinoma. Cancer.
62:2558–2563. 1988. View Article : Google Scholar : PubMed/NCBI
|
|
3
|
Kaur A and Jayaram G: Thyroid tumors:
Cytomorphology of medullary, clinically anaplastic and
miscellaneous thyroid neoplasms. Diagn Cytopathol. 6:383–389. 1990.
View Article : Google Scholar : PubMed/NCBI
|
|
4
|
Chetty R, Clark SP and Dowling JP:
Leiomyosarcoma of the thyroid: Immunohistochemical and
ultrastructural study. Pathology. 25:203–205. 1993. View Article : Google Scholar : PubMed/NCBI
|
|
5
|
Iida Y, Katoh R, Yoshioka M, Oyama T and
Kawaoi A: Primary leiomyosarcoma of the thyroid gland. Acta Pathol
Jpn. 43:71–75. 1993.PubMed/NCBI
|
|
6
|
Ozaki O, Sugino K, Mimura T, Ito K, Tamai
S and Hosoda Y: Primary leiomyosarcoma of the thyroid gland. Surg
Today. 27:177–180. 1997. View Article : Google Scholar : PubMed/NCBI
|
|
7
|
Thompson LD, Wenig BM, Adair CF, Shmookler
BM and Heffess CS: Primary smooth muscle tumors of the thyroid
gland. Cancer. 79:579–587. 1997. View Article : Google Scholar : PubMed/NCBI
|
|
8
|
Tsugawa K, Koyanagi N, Nakanishi K, Wada
H, Tanoue K, Hashizume M and Sugimachi K: Leiomyosarcoma of the
thyroid gland with rapid growth and tracheal obstruction: A partial
thyroidectomy and tracheostomy using an ultrasonically activated
scalpel can be safely performed with less bleeding. Eur J Med Res.
4:483–487. 1999.PubMed/NCBI
|
|
9
|
Tulbah A, Al-Dayel F, Fawaz I and Rosai J:
Epstein-Barr virus-associated leiomyosarcoma of the thyroid in a
child with congenital immunodeficiency: A case report. Am J Surg
Pathol. 23:473–476. 1999. View Article : Google Scholar : PubMed/NCBI
|
|
10
|
Takayama F, Takashima S, Matsuba H,
Kobayashi S, Ito N and Sone S: MR imaging of primary leiomyosarcoma
of the thyroid gland. Eur J Radiol. 37:36–41. 2001. View Article : Google Scholar : PubMed/NCBI
|
|
11
|
Day AS, Lou PJ, Lin WC and Chou CC:
Over-expression of c-kit in a primary leiomyosarcoma of the thyroid
gland. Eur Arch Otorhinolaryngol. 264:705–708. 2007. View Article : Google Scholar : PubMed/NCBI
|
|
12
|
Just PA, Guillevin R, Capron F, Le
Charpentier M, Le Naour G, Menegaux F, Leenhardt L, Simon JM and
Hoang C: An unusual clinical presentation of a rare tumor of the
thyroid gland: Report on one case of leiomyosarcoma and review of
literature. Ann Diagn Pathol. 12:50–56. 2008. View Article : Google Scholar : PubMed/NCBI
|
|
13
|
Mansouri H, Gaye M, Errihani H, Kettani F
and Gueddari BE: Leiomyosarcoma of the thyroid gland. Acta
Otolaryngol. 128:335–336. 2008. View Article : Google Scholar : PubMed/NCBI
|
|
14
|
Wang TS, Ocal IT, Oxley K and Sosa JA:
Primary leiomyosarcoma of the thyroid gland. Thyroid. 18:425–428.
2008. View Article : Google Scholar : PubMed/NCBI
|
|
15
|
Bertelli AA, Massarollo LC, Volpi EM, Ueda
RY and Barreto E: Thyroid gland primary leiomyosarcoma. Arq Bras
Endocrinol Metabol. 54:326–330. 2010.(In Portuguese). View Article : Google Scholar : PubMed/NCBI
|
|
16
|
Amal B, El Fatemi H, Souaf I, Moumna K and
Affaf A: A rare primary tumor of the thyroid gland: Report a new
case of leiomyosarcoma and literature review. Diagn Pathol.
8:362013. View Article : Google Scholar : PubMed/NCBI
|
|
17
|
Ege B and Leventoğlu S: Primary
leiomyosarcoma of the thyroid. J Korean Surg Soc. 85:43–46. 2013.
View Article : Google Scholar : PubMed/NCBI
|
|
18
|
Mouaqit O, Belkacem Z, Ifrine L, Mohsine R
and Belkouchi A: A rare tumor of the thyroid gland: Report on one
case of leiomyosarcoma and review of literature. Updates Surg.
66:165–167. 2014. View Article : Google Scholar : PubMed/NCBI
|
|
19
|
Tanboon J and Keskool P: Leiomyosarcoma: A
rare tumor of the thyroid. Endocr Pathol. 24:136–143. 2013.
View Article : Google Scholar : PubMed/NCBI
|
|
20
|
Bathan AJ, Constantinidou A, Pollack SM
and Jones RL: Diagnosis, prognosis, and management of
leiomyosarcoma: recognition of anatomic variants. Curr Opin Oncol.
25:384–389. 2013. View Article : Google Scholar : PubMed/NCBI
|
|
21
|
Agrawal M, Uppin SG, Challa S and Prayaga
AK: Carcinosarcoma thyroid: An unusual morphology with a review of
the literature. South Asian J Cancer. 2:2262013. View Article : Google Scholar : PubMed/NCBI
|
|
22
|
Naqiyah I, Zulkarnaen AN, Rohaizak M and
Das S: Carcinosarcoma of the thyroid: A case report. Hippokratia.
14:141–142. 2010.PubMed/NCBI
|
|
23
|
Edris B, Weiskopf K, Volkmer AK, Volkmer
JP, Willingham SB, Contreras-Trujillo H, Liu J, Majeti R, West RB,
Fletcher JA, et al: Antibody therapy targeting the CD47 protein is
effective in a model of aggressive metastatic leiomyosarcoma. Proc
Natl Acad Sci USA. 109:6656–6661. 2012. View Article : Google Scholar : PubMed/NCBI
|